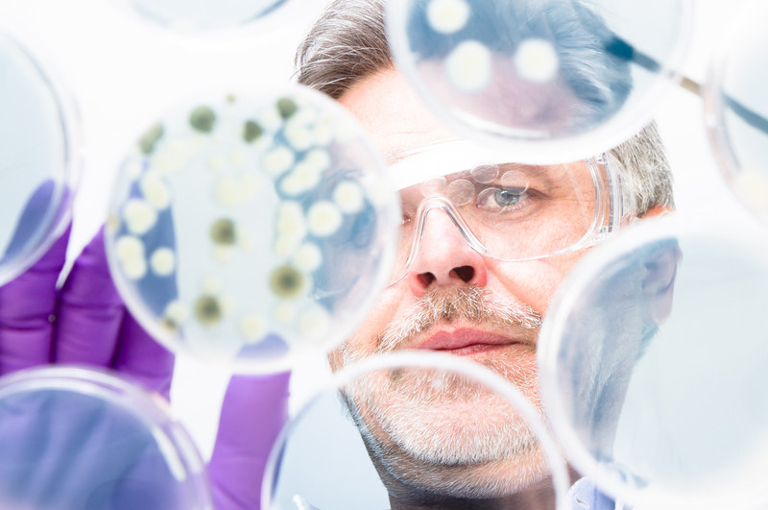
Antimikrobna rezistencija pojavljuje se kao sporo napredujuća globalna pandemija

Antimikrobna rezistencija pojavljuje se kao sporo napredujuća globalna pandemija
Diljem svijeta uobičajene infekcije postaju sve teže za liječiti. Novi pregled prikazuje otrežnjujuću sliku globalne antimikrobne rezistencije (AMR), prateći kako se bakterije i gljivice razvijaju brže nego što medicina može reagirati. Uspoređujući podatke o rezistenciji iz više sustava nadzora, znanstvenici su identificirali alarmantne trendove: rastuću otpornost na antibiotike posljednje linije, regionalne nejednakosti i brzo širenje rezistentnih gena putem globalnih putovanja i poljoprivrede.
Desetljeća prekomjerne upotrebe antibiotika - u bolnicama, zajednicama i na farmama - potaknula su globalni porast rezistentnih mikroba. Ove superbakterije uspijevaju tamo gdje se antibiotici slobodno koriste i slabo reguliraju, tiho se šireći kroz ljude, životinje i okoliš.
Escherichia coli i Klebsiella pneumoniae ostaju i dalje najveće prijetnje, sa sojevima koji proizvode β-laktamaze raširenim u Aziji i varijantama otpornim na karbapenem u porastu diljem Europe i Amerike. Zloglasne Acinetobacter baumannii i Pseudomonas aeruginosa posebno je teško liječiti, pokazujući razinu otpornosti od preko 70% u nekim regijama svijeta. Nasuprot tome, sjeverna Europa bilježi jednoznamenkaste stope, što odražava učinkovito upravljanje.
Što se tiče gljivičnih infekcija, Candida auris se pojavila kao gotovo pan-rezistentni patogen, dok Aspergillus fumigatus razvija otpornost na azole, dijelom potaknutu upotrebom poljoprivrednih fungicida.
Ipak, pregled također nudi nadu - ukazujući na inovativne kombinacije lijekova i strategije liječenja temeljene na preciznosti koje bi mogle pomoći u ponovnom preuzimanju kontrole nad ovom rastućom krizom, a pametno propisivanje i globalna suradnja jednako su važni kao i novi lijekovi u borbi protiv otpornosti.
Izvor:
Medical Journal of Peking Union Medical College Hospital








